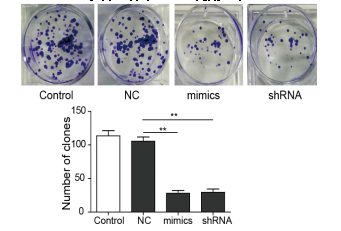

克隆形成
目錄價
¥ 0.00
一鍵復(fù)制產(chǎn)品信息
產(chǎn)品推薦
聯(lián)系方式
- 電話:400-1016-218
- 郵箱:355185756@qq.com
- 地址:安徽省合肥市高新區(qū)黃山路602號合肥國家大學(xué)科技園A401室
產(chǎn)品詳情
應(yīng)用范圍
通過改變各種理化因素,可能導(dǎo)致細胞的克隆形成能力發(fā)生改變。通過一定的實驗方法可以對細胞的克隆形成能力進行檢測。可通過克隆形成在細胞水平測試能夠抑制腫瘤細胞的克隆形成的藥物。
匹配醫(yī)學(xué)研究方向:腫瘤科,消化科等等。
優(yōu)勢/優(yōu)點:
操作簡便、細胞間分泌的促生長因子可在培養(yǎng)液中擴散、克隆形成率高,適用于貼壁生長的細胞。
結(jié)果展示:
常見問題
答:公司提供兩種運輸方式供老師選擇,1、復(fù)蘇的活細胞:采用常溫發(fā)貨的方式,收到即可觀察密度并判斷是否進行傳代操作。優(yōu)勢是省去復(fù)蘇的步驟,細胞成活率較高。2、凍存的細胞:采用干冰運輸,一般情況下發(fā)貨是2支凍存管,收到后放-80過夜,第二天轉(zhuǎn)入液氮長期存儲,擇機復(fù)蘇。優(yōu)勢是發(fā)貨快,一般一兩天即可收到,缺點是需要自己復(fù)蘇。
答:我公司提供的細胞大部分都參考資源庫的培養(yǎng)信息,如ATCC、DSMZ、中科院等等官方平臺。也有少部分細胞為客戶提供了替代培養(yǎng)方案,根據(jù)客戶的意愿進行選擇!
答:不可以重復(fù)使用,一般從我公司發(fā)出的細胞都需要達到一定的密度后發(fā)出,充液的培養(yǎng)基血清比例會比正常培養(yǎng)時所用到的培養(yǎng)液低很多,通常在3-5%,以維持細胞存活,控制生長速度,不可以用來做細胞培養(yǎng)使用。
答:細胞在鏡下發(fā)現(xiàn)圓形的白色的點點,一般情況下是為貼壁的細胞或脫落的細胞死亡后的產(chǎn)物,懸浮細胞也會有這種現(xiàn)象,出現(xiàn)圓形的光圈一樣的圓點。通常,白色的圓點是分散分布的,聚團類的懸浮細胞可能會聚團出現(xiàn)白色的亮斑,技術(shù)老師可以繼續(xù)培養(yǎng)并觀察。
答:一般情況下,我公司建議客戶收到細胞后傳1-2代后即可安排凍存留種,可先凍存1-2支凍存管,凍存的細胞數(shù)量多一些,便于后期復(fù)蘇。購買原代細胞的客戶,要充分考慮該細胞的傳代次數(shù)限制,人源原代細胞大概可以傳7代左右,鼠源的可以傳3代左右,對于一些能傳代次數(shù)很少的原代細胞,不建議凍存,收到后調(diào)整狀態(tài)后即可安排實驗。















皖公網(wǎng)安備 34010402703761號
郭經(jīng)理:3554285629






